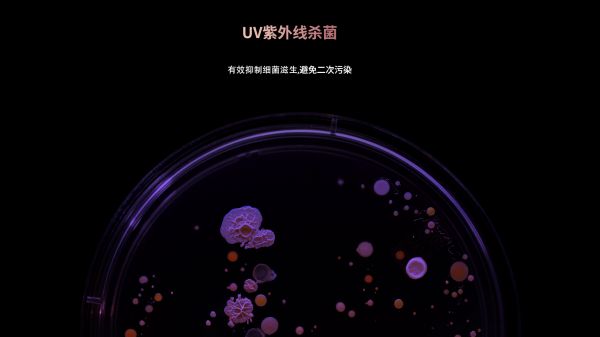

朗诗德灵泷X Pro净水器全新上市:智能科技重塑健康饮水体验

近日,知名净水品牌朗诗德正式推出灵泷X Pro净水器。自朗诗德灵泷系列净水器上市以来,凭借其卓越的净水性能和时尚简约的设计风格,迅速成为都市家庭的首选。灵泷系列产品深受消费者喜爱,以「巧」、「净」、「智」、「轻」作为核心优势,让纯净好水改善万千家庭的生活品质,一举成为高端净水器市场的标杆产品。
作为灵泷系列的全新升级产品,此次发布的灵泷X Pro在杀菌技术、智能交互和硬件设计等方面实现重大突破,将为消费者带来更贴心、更智能的饮水体验。
#轻奢大气黑金配色
灵泷X Pro以轻盈机身隐于橱下,黑色面板搭配晶格纹理,点缀玫瑰金色线条,大气不凡。整机小巧,仅有40cm, 有限空间中演绎无限净水可能,赋予现代家居独特简约美感。

#紫外线杀菌技术护航
灵泷X Pro引入UV紫外线杀菌功能,有效抑制水中细菌滋生,避免二次污染。该技术配合母婴级安全材质,为家庭饮水提供更全面的健康保障。
#智能双显系统升级
产品采用创新的双显示屏设计:升级版智能龙头配备高清液晶显示屏,实时显示水质TDS值和单次用水量;机身智能屏显,同步显示原水水质和滤芯状态。

#高端龙头硬件革新
全新设计的智能龙头,硬朗耐看金属外形,手感舒适。采用优质材质和龙头内部灌胶工艺,一体防水防泼溅,使用更无后顾之忧。
#延续灵泷系列卓越性能
沿袭灵泷系列优良基因,带领用户突破传统净水器体验,带来更舒适的健康高品质生活!整机高度仅40cm,灵活适用厨下空间。拥有灵泷系列独特的专利Dual-stroke滤芯结构,一推一拉,即可轻松换芯。晶格磁吸面板更是方便后续维护。

灵泷X Pro依旧像所有灵泷系列的净水器一样,搭载「巧净」滤芯系统,双芯七重高效过滤,有效拦截重金属、细菌、病毒、农药残留等有害物质,让每一刻直饮都安心。灵泷X Pro拥有800g大通量,2升/分钟澎湃流量,煲汤煮茶都无需等待!三大冲洗模式,滤芯自洁更加便捷。

灵泷X Pro可运用手机,通过「朗诗德云管家」,随时查看机器状态和用水情况,远程也能完成冲洗滤芯的动作。同时通过AI算法,智能计算滤芯寿命,何时需要更换滤芯一目了然。低噪音设计让灵泷X Pro运行轻柔稳定,静音制水不打扰。

朗诗德灵泷X Pro净水器的问世,不仅代表着朗诗德在净水技术领域的又一次探索,更展现了科技与健康生活的完美融合。从紫外线杀菌到智能双显系统,从人性化设计到高效净水性能,每一处细节都致力于为用户提供更安全、更便捷的饮水体验。朗诗德将继续以创新为驱动,为消费者带来更多高品质的净水解决方案,让健康饮水成为现代生活的标配。即刻体验灵泷X Pro,开启您的智能净水新时代!
网址:朗诗德灵泷X Pro净水器全新上市:智能科技重塑健康饮水体验 https://www.jiaju82.com/news-view-id-881687.html

